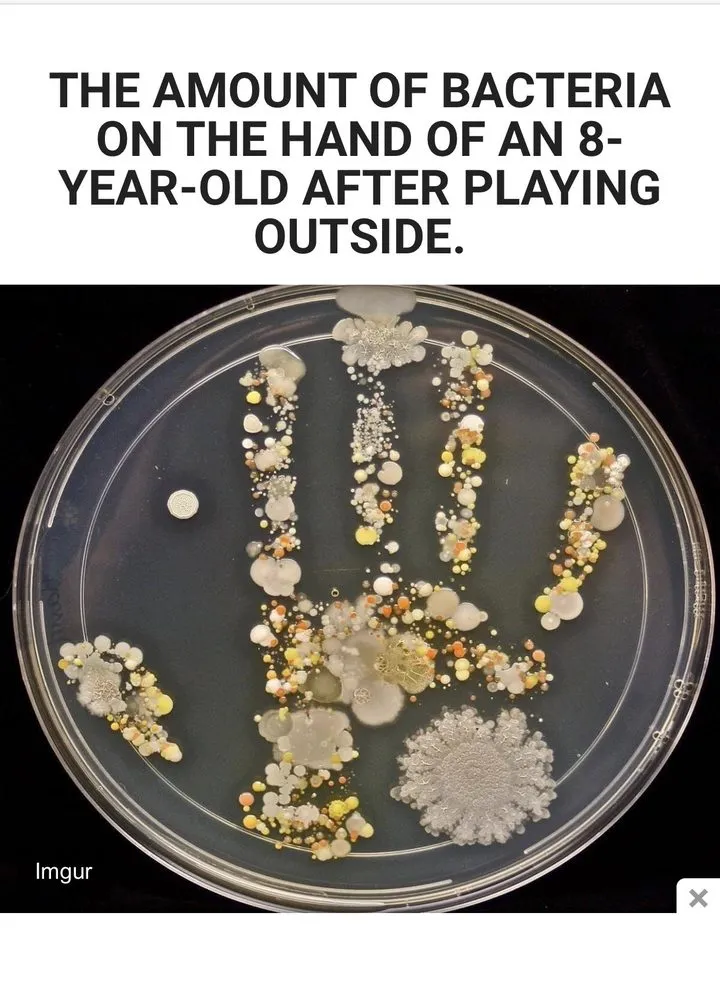
Slide of K & S Plumbing

K & S Plumbing - Evadale's Expert Plumbing Service
Evadale, TX 77615
Company Profile
K & S Plumbing is a locally owned and operated plumbing service proudly serving Evadale and the surrounding Golden Triangle area. Founded on a commitment to the community, the company brings deep roots in Southeast Texas to every job. We focus on providing reliable, clean, and quality plumbing solutions for homeowners, backed by licensed professionals who have passed state board background checks. Our approach is straightforward: honest communication, fair pricing, and a dedication to solving your plumbing problems right the first time. We understand the specific needs of local homes, from common water heater issues to aging pipe systems, and are here to provide dependable service you can trust.
FAQs
My water heater in Evadale isn't heating properly. Could sediment be the issue, and can you help?
Yes, sediment buildup from our local water supply is a common cause of reduced efficiency and premature failure in water heaters here in Evadale. K & S Plumbing can perform a thorough inspection, flush the system to remove sediment, and repair any damaged components like the heating element or anode rod. If a replacement is needed, we handle the full installation with all required permits and code compliance.
What does your plumbing inspection service cover for an older home in Evadale?
Our comprehensive plumbing inspection for Evadale homes includes checking for leaks, testing water pressure, assessing pipe condition (including shutoff valves, which commonly fail in older systems), inspecting water heaters for sediment and corrosion, and evaluating drains and sewer lines. We provide a detailed report with honest recommendations for repair or maintenance to help prevent emergencies and protect your property.
Do you handle both installation and repair for garbage disposals?
Absolutely. K & S Plumbing provides complete garbage disposal services. For installations, we ensure proper electrical and plumbing connections for safe, reliable operation. For repairs, we diagnose issues like jams, leaks, or motor failure. Our technicians carry common parts and can often resolve the problem in a single visit, getting your kitchen back in working order quickly.
Business Offerings
- Hot water recirculation pump repair
- Sump pump repair
- Gas line repair
- Sewer installation
- Plumbing inspection
Business Location & Hours
| Mon: | 8:00 AM - 4:30 PM |
| Tue: | 8:00 AM - 4:30 PM |
| Wed: | 8:30 AM - 4:30 PM |
| Thu: | 8:00 AM - 4:30 PM |
| Fri: | 8:00 AM - 3:30 PM |
| Sat: | Closed |
| Sun: | Closed |